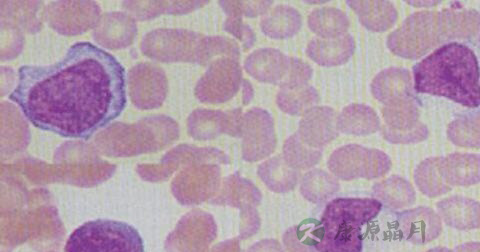

人体血液中存在着几种血液细胞。红细胞和粒细胞等被称之为终末细胞,意为它们的生命没有回头路,必须一直走下去,直至死亡。这样的细胞除了行使各自的功能,不再进行任何形式的改变。而淋巴细胞不是终末细胞,它还可以发生一些变化,比如原始细胞化和幼稚细胞化(俗称“返祖现象”)。显微镜目测法:<2%。
异型淋巴细胞数量增多可能是因为传染性单核细胞增多症、流行性出血热早期及病毒性肝炎、风疹、麻疹、腮腺炎、乙型脑炎、淋巴细胞白血病等病毒性感染。
异型淋巴细胞数量增多不一定就是淋巴细胞白血病。比如,有一种叫作“传染性单核细胞增多症”的疾病,就可以出现血液中异型淋巴细胞增多,甚至达20%~30%。(参考值为<10%)。这种病为EB病毒感染,多数是经唾液感染,可以通过检查血液中EB病毒的抗体来证实感染的存在。其他病毒的感染有时也会出现同样的反应,有的药物也会引发淋巴细胞的应激反应,所以出现几个异型淋巴细胞时不必草木皆兵。但是,如果异型淋巴细胞数量持续增多,则不能大意,还应该再做一些其他的检查,比如淋巴细胞免疫分型、细胞化学染色等,以排除淋巴细胞白血病。
人体血液中存在着几种血液细胞。红细胞和粒细胞等被称之为终末细胞,意为它们的生命没有回头路,必须一直走下去,直至死亡。这样的细胞除了行使各自的功能,不再进行任何形式的改变。
而淋巴细胞不是终末细胞,它还可以发生一些变化,比如原始细胞化和幼稚细胞化(俗称“返祖现象”)。这样的变化通常是由病毒或者药物引起的应激反应,在显微镜下可以看到其细胞体积变大,细胞核体积也增大,细胞浆颜色加深,出现空泡等。这与正常淋巴细胞形态有明显不同。这时候,就应报告发现异型淋巴细胞。人体异性淋巴细胞正常值为0-2.0%。

异型淋巴细胞(abnormallymphocyte)是一种形态变异的淋巴细胞,免疫表型显示多属T淋巴细胞。其形态变异是病毒或某些过敏原等因素刺激,T淋巴细胞反应性增生甚至发生母细胞化所致。正常人血片中偶可见到异型淋巴细胞。某些病毒感染,如EB病毒、巨细胞病毒、风疹病毒、肝炎病毒等均可见淋巴细胞增高,并出现数量不等的异型淋巴细胞。其中以EB病毒感染导致的传染性单核细胞增多症表现尤为显着,异型淋巴细胞10%,对其诊断具有一定价值。
询问病史 引起外周血出现异形淋巴细胞的原因主要为病毒感染,其次为细菌、真菌感染及过敏性疾病等,询问病史时需注意:
1、发热:异形淋巴细胞增多伴发热,需考虑感染如传染性单核细胞增多症、流行性出血热、急性腮腺炎等。流行性出血热时大多出现突然畏寒发热,体温在1~2日内可达39~40℃,热型以弛张及稽留为多,一般持续3~7日。出现全身中毒症状,高度乏力,全身酸痛,头痛和剧烈腰痛、眼眶痛,称为“三痛”。发热为周期性寒战发热交替则注意疟疾感染。免疫系统疾病时也可合并反复低热。
2、起病缓急:短期内出现发热等症状伴异形淋巴细胞增多须考虑急性期的感染。而异形淋巴细胞持续增多。且无明显变化则需当心慢性肝炎,异常细胞克隆性增殖性疾病和免疫系统疾病。
3、接触史:因异形淋巴细胞增多和许多传染性疾病有关,如流行性出血热、螺旋体病、立克次体病或原虫感染如疟疾等,故应详细询间接触史,包括疫区居留史、家畜接触史等。
4、既往史:既往是否有结核病,疟疾等传染病史;有无肝炎病毒感染史;有无输血史;有无急慢性肾功能不全、血液透析史;有无特殊药物服用史,服用过程中有无出现皮疹、瘙痒等过敏情况;有无放射治疗史;有无体外循环手术史等,详尽的既往史资料可以帮助更快的找到病因。
豫公网安备 41110202000246号互联网药品信息服务资格证书:(豫)-经营性-2022-0039增值电信业务经营许可证:豫B2-20221313医疗器械经营备案编号:豫郑食药监械经营备20212188号



